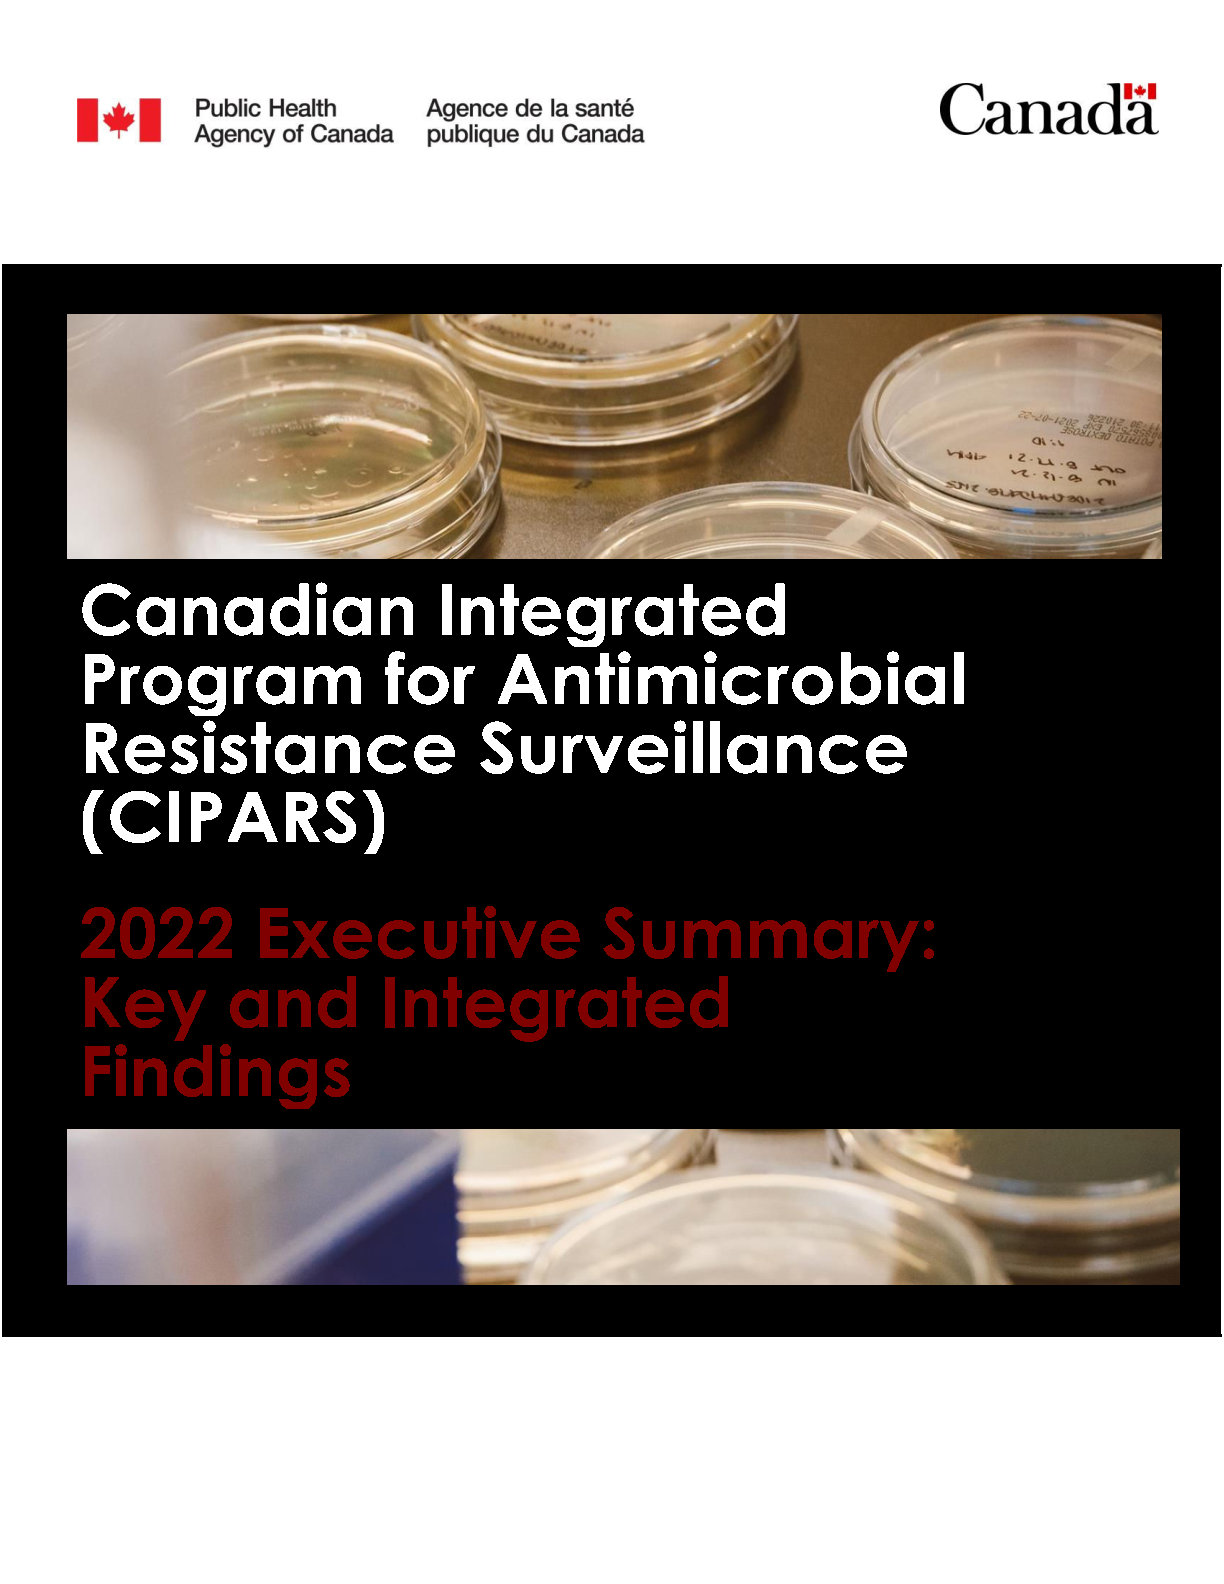

Canadian Integrated Program for Antimicrobial Resistance Surveillance (CIPARS) 2022 Executive Summary: Key and Integrated Findings
Download the alternative format
(PDF format, 260.1 KB, 9 pages)
Organization: Public Health Agency of Canada
Published: 2024-03-XX
Table of contents
- CIPARS 2022 Executive summary: Key and integrated findings
- A tribute to Dr. Michael Mulvey
- Integrated antimicrobial sales data
- Resistance to antimicrobials of very high importance to human medicine
- Integrated antimicrobial resistance findings
- Integrated antimicrobial use and resistance findings
- Antimicrobial resistance in animal pathogens
- Important: Laboratory method change affecting reporting of results
CIPARS 2022 Executive summary: Key and integrated findings
The Canadian Integrated Program for Antimicrobial Resistance Surveillance (CIPARS) monitors trends in antimicrobial use (AMU) and antimicrobial resistance (AMR) in select foodborne bacterial species from people, animal, and food sources across Canada.
Please see the CIPARS web pages for more detailed information on AMU and AMR by surveillance component, host species, and bacterial species.
A tribute to Dr. Michael Mulvey
We dedicate this work in memory of our colleague, mentor, and friend: Dr. Michael (Mike) R. Mulvey. This "Super-Bug Fighter" was passionate and committed to the battle against AMR. He was a pillar to the CIPARS program from its inception over 20 years ago and his contributions (intellect, experience, and resourcefulness) were instrumental to the conception, design, and expansion of the program. Mike's legacy will echo in CIPARS for countless years to come as we work to support measures to contain the emergence and spread of AMR.
Integrated antimicrobial sales data
Veterinary antimicrobial sales reporting (VASR) data
While sales of medically important antimicrobials have decreased overall since 2018 by 11% (after adjusting for animal biomass), the quantity of antimicrobial sales has remained fairly stable since 2019. It is important to note that the first two years of VASR (2018, and 2019) was a time of regulatory and policy changes implemented by Health Canada to promote the responsible use of antimicrobials in animals. Since 2018, antimicrobial sales (after adjusting for animal biomass) have decreased for pigs, poultry, and aquaculture, and increased for cattle, cats and dogs, horses, and small ruminants.
While the majority of antimicrobial sales continue to be Category II and III antimicrobials, and the quantity of Category I antimicrobials sold was relatively small, there was a 6% increase in Category I antimicrobial sales (adjusted for biomass) between 2021 and 2022.
In 2022, there were more than 22 times more animals than people in Canada. When we considered the quantity of antimicrobial sales in kilograms, 80% of antimicrobials were sold for use in production animals (including food animals and horses), 19% for humans, less than 1% for cats and dogs, and less than 1% for crops. When providing the necessary context of the relevant biomass, 1.5 times more antimicrobials were sold for use in production animals than people.
Resistance to antimicrobials of very high importance to human medicineReference 1
Extended-spectrum beta-lactamase-producing Salmonella
- Extended-spectrum beta-lactamase (ESBL)-producing Salmonella from humans, animals, and food is increasing.
- The frequency of ESBL-producing Salmonella prior to 2017 (the total number of isolates tested was n = 30,303) was less than 0.5% for each of humans and animals.
- The frequency of ESBL-producing Salmonella in 2022 (the total number of isolates tested was n = 6,833) was 1.5% for each of human and animals.
- There were some common ESBL-producing Salmonella strains found across human and animal/meat sources, including some outbreak strains.
- CTX-M-65 Salmonella Infantis
- This is an emerging strain in poultry. Closely-related strains from humans (n = 166), healthy chickens (n = 3), healthy turkeys (n = 12), and raw chicken from grocery stores (n = 15) were found.
- CTX-M-55 Salmonella Typhimurium
- Closely related strains from cattle (n = 6) and humans (n = 1) were found.
- CTX-M-55 Salmonella I 4,[5],12:i:-
- Closely related strains from a sick pig (diagnostic sample) and humans were found.
- An investigation of a cluster in 2022 to 2023 linked human isolates (n = 40) of CTX-M-55 Salmonella I 4,[5],12:i:- in several provinces, but primarily Ontario and Québec, to strains from beef cattle (n = 17), pigs (n = 3), dogs (n= 3), mixed ground meat (n = 1), and raw pet food (n = 1).
- CTX-M-65 Salmonella Infantis
Carbapenem resistance
- Carbapenem resistance was only found in Salmonella isolates from a sick pig (2017) and one human sample (2018).
Mobile colistin resistance
- Human: No mobile colistin resistance was found in Salmonella in 2021 and 2022. There were 17 isolates with mobile colistin resistance detected between 2017 and 2020.
- Animals and food: Mobile colistin resistance has not been detected in submitted isolates of Salmonella and E. coli.
Resistance to other antimicrobials of very high importance to human medicine, including resistance to ciprofloxacin, are reported in the relevant CIPARS components below.
Integrated antimicrobial resistance findings
Human
Salmonella: Since 2020, resistance profiles for all human Salmonella (approximately 5000 per year) has been determined using whole genome sequencing (WGS)Reference 2.
- Serovar distribution: The distribution of non-typhoidal Salmonella serovars was similar to previous years: S. Enteritidis (41%), S. Typhimurium (8%), S. Newport (5%), S. Infantis (3%), S. Heidelberg (2%), and S. Stanley (2%).
- Type of infections: For these serovars, the majority of infections (more than 73%) would be considered non-invasive (gastrointestinal).
- Overall AMR: The occurrence of AMR varies by serovar. Salmonella Enteritidis and S. Typhimurium were the most commonly reported serovars. For these two serovars, resistance genes/mutations (those validated for AMR prediction) were not detected in over 50% of the isolates.
- Resistance to 3 or more antimicrobial classes: Most commonly detected in
- Salmonella I 4,[5],12:i:- (51%), followed by S. Newport (39%), S. Infantis (38%), and S. Typhimurium (23%).
- Resistance to 5 or more antimicrobial classes: There was predicted resistance to 7 classes in 30% of S. Newport, while 83% of S. Dublin had predicted resistance to either 5 or 6 antimicrobial classes.
- Resistance to Category I antimicrobials: The range of predicted resistance/non-susceptibilityReference 3 to all Category I antimicrobials ranged between less than 10% (S. Typhimurium and S. Heidelberg) to 50% (S. Infantis). For the serovars with the highest occurrence of resistance/non-susceptibility, the occurrence of non-susceptibility to ciprofloxacin was: 47% for S. Infantis, 46% for S. Enteritidis, 35% for S. Newport, and 13% for Salmonella I 4,[5],12:i:-. The occurrence of resistance to ceftriaxone was: 23% for S. Infantis, 8% for Salmonella I 4,[5],12:i:-, 2% for S. Newport, and less than 1% for S. Enteritidis.
Campylobacter: Campylobacter isolates for antimicrobial susceptibility testing were made available to CIPARS through FoodNet Canada and its community-based sentinel site surveillance for foodborne and waterborne diseases, and exposures (2017 to 2021). This reporting is new to CIPARS.
- Campylobacter species (2021): The distribution of Campylobacter species was similar across years: C. jejuni (91% of isolates tested), C. coli (7%) with the remaining species (C. upsaliensis, C. lari, C. fetus, C. ureolyticus) occurring at frequencies of less than 1%.
- Overall AMR: Resistance was most commonly reported to ciprofloxacin and tetracycline. Resistance to one or more classes occurred in 57% of C. jejuni and 62% of C. coli isolates. Resistance to 5 (of 6) antimicrobial classes was found in 1% of C. jejuni isolates and not in C. coli.
- Ciprofloxacin resistance: For C. jejuni, there was a general decreasing trend in resistance to ciprofloxacin from 2017 (32%) to 2021 (24%) with an increase to 46% in 2019. The number of isolates per year for C. coli was too low (less than 30) to robustly describe trends in AMR, however resistance ranged from 32% to 70% depending on the year.
Extensively drug-resistant Salmonella I 4,[5],12:i:- from humans
Extensively drug-resistant (XDR) Salmonella I 4,[5],12:i:- (resistant to ampicillin, ceftriaxone, ciprofloxacin, azithromycin, trimethoprim/sulfonamides) was found within the CIPARS program in 2021 (n = 7) and 2022 (n = 14), including cases in children. Extensively drug-resistant Salmonella I 4,[5],12:i- has not been observed in the animal or food components of CIPARS.
Nalidixic acid resistance in Salmonella Enteritidis from broiler chickens and raw chicken meat
Starting in 2018, nalidixic acid-resistant S. Enteritidis from broiler chicken(s) was observed in a small but notable number of isolates from multiple CIPARS components. Historically, the majority of S. Enteritidis isolates from CIPARS were susceptible to all tested antimicrobials. In 2022, CIPARS continued to observe nalidixic acid-resistant S. Enteritidis from healthy broiler chickens on farm (n = 15), samples from healthy chickens at abattoir (n = 9), samples of grocery store chicken (n = 12), and samples from sick chickens (n = 11); recognizing that sick animals do not enter the food chain.
Gentamicin resistance in Campylobacter from animals and food (raw retail meat)
Historically, gentamicin resistance was not observed in Campylobacter in animals and food from CIPARS components. However, since 2019, gentamicin resistance in Campylobacter was observed in multiple CIPARS components. Starting in 2019, a gentamicin-resistant Campylobacter isolate (n = 1) was found in a sample from feedlot cattle. At abattoir, resistance to gentamicin was found in isolates from pigs (n = 2 isolates), and from chickens (n = 1 isolate) in 2021, and in 2022 from cattle (n = 2 isolates), and pigs (n = 1 isolate). From grocery stores, resistance to gentamicin was not found from chicken and turkeyReference 4.
Enterococcus from poultry (2021; most recent data available) and feedlot cattle on farm and antimicrobial resistanceReference 5
Broiler chickens: In 2021, the most common Enterococcus species recovered was E. faecalis (63%), followed by E. faecium (22%)Reference 6. Resistance to vancomycin, tigecycline, daptomycin, or linezolid was not observed. Resistance to ampicillin or nitrofurantoin was not observed in E. faecalis. However, 7% of E. faecalis were resistant to gentamicin, 2% were resistant to avilamycin, and less than 1% were resistant to ciprofloxacin. For E. faecium, 83% of isolates were resistant to quinupristin-dalfopristin, 36% to ciprofloxacin, 21% were resistant to each of avilamycin and nitrofurantoin, and 5% were resistant to ampicillin. Gentamicin resistance was not observed in E. faecium.
Layer chickens: In 2021, the most common species recovered was E. faecalis (83%), followed by E. faecium (9%)Reference 7. Resistance to ampicillin, avilamycin, chloramphenicol, daptomycin, linezolid, nitrofurantoin, tigecycline, or vancomycin was not observed. Gentamicin resistance (3%) was observed in E. faecalis. For E. faecium, 50% (n = 4) of isolates were resistant to quinupristin-dalfopristin and 25% (n = 2) were resistant to ciprofloxacin.
Turkeys: In 2021, the most common species recovered was E. faecalis (75%), followed by E. faecium (15%)Reference 8. Resistance to ampicillin, chloramphenicol, linezolid, tigecycline, or vancomycin was not observed. Resistance to ciprofloxacin or daptomycin were not observed in E. faecalis. However, 3% of E. faecalis were resistant to avilamycin, and 2% were resistant to gentamicin. For E. faecium, 89% of isolates were resistant to quinupristin-dalfopristin, 56% to ciprofloxacin, 30% to nitrofurantoin, and 22% were resistant to avilamycin.
Feedlot cattle: In 2022, the Enterococcus species recovered were E. hirae (63%), E. faecalis (16%), E. faecium (16%), E. casseliflavus (2%), E. durans (2%), and E. gallinarium (0.6%)Reference 9. Resistance to gentamicin or vancomycin was not observed in any Enterococcus isolates. Resistance to linezolid or penicillin was not observed in E. hirae. However, 39% of E. hirae were resistant to quinupristin-dalfopristin, 25% were resistant to daptomycin, 7% were resistant to tigecycline, and 1% were resistant to each of ciprofloxacin, and nitrofurantoin. For E. faecalis, resistance to nitrofurantoin or penicillin was not observed. However, 10% of E. faecalis isolates were resistant to tigecycline, 4% of isolates were resistant to linezolid, and 2% were resistant to daptomycin. For E. faecium, there was no resistance to linezolid. However, 26% of E. faecium isolates were resistant to quinupristin-dalfopristin, 18% of isolates were resistant to daptomycin, 16% were resistant to ciprofloxacin, 4% were resistant to tigecycline, and 2% were resistant to each of nitrofurantoin and penicillin.
Integrated antimicrobial use and resistance findings
Reported Category I antimicrobial use and Category I antimicrobial resistance in isolates from healthy animals or food
Category I reported AMU on farm: In 2022, the reported use of Category I antimicrobials from CIPARS volunteer sentinel farms (broiler chicken, turkey, grower-finisher pigs, and feedlot cattle), was a very small fraction of the overall reported AMU (less than 0.2%).
Ceftriaxone-resistant E. coli and SalmonellaReference 10: The trend (2018 to 2022), and observation of ceftriaxone resistance in E. coli and Salmonella from multiple surveillance components (samples from healthy animals at farm, abattoir, and raw meat from grocery stores) showed similar patterns. The general trend in resistance was either decreasing or stable.
- For ceftriaxone-resistant E. coli, the frequency of resistance ranged from 0% to 3% for isolates collected from healthy animals on farms, at abattoir or raw meat from grocery stores.
- For ceftriaxone-resistant Salmonella from healthy broiler chickens, there was a decrease from 13% to 5% on farms, a decrease at abattoir from 8% to 5%, and a decrease in raw chicken from grocery stores from 11% to 7%.
- For ceftriaxone-resistant Salmonella from grower-finisher pigs, there was a decrease from 8% to 6% from samples from farms with a low stable frequency of resistance in samples from abattoirs (2% to 3%).
- The frequency of ceftriaxone resistance in Salmonella from healthy turkeys on farms and raw turkey from grocery stores ranged from 0% to 2%.
Ciprofloxacin-resistant CampylobacterReference 11: The trend (2018 to 2022) in ciprofloxacin resistance in Campylobacter from multiple surveillance components (samples from healthy animals at farm, abattoir, and raw meat from grocery stores) showed similar patterns. The general trend in resistance was increasing.
- For healthy broiler chickens, there was an increase from 12% to 34% on farms, an increase at abattoir from 20% to 25%, and an increase in raw chicken from grocery stores from 20% to 25%.
- For healthy feedlot cattle, there was an increase from 18% to 42%. There was an increase from 20% to 25% in healthy cattle at abattoir.
- For grower-finisher pigs, there was also an increase from 11% to 15% on farms, and from 10% to 14% at abattoir.
- The exceptions were decreasing trends in ciprofloxacin resistance from samples from healthy turkeys (38% to 11%), and healthy dairy cattle (20% to 16%) on farms.
Antimicrobial resistance in animal pathogens
Starting in 2019, CIPARS collected antimicrobial resistance data on three major bovine respiratory disease (BRD) pathogens (Mannheimia haemolytica, Pasteurella multocida, Histophilus somni) from feedlot cattle. In 2022, resistance was observed in 10% or less of the BRD bacterial isolates recovered from nasopharyngeal samples of healthy cattle collected at arrival to the feedlot. Resistance varied by BRD bacteria, and was observed in up to 61% of isolates when cattle were tested later in the feeding period at rehandling. Less than 5% of isolates were resistant to Category I antimicrobials.
Important: Laboratory method change affecting reporting of results
Antimicrobial resistance prediction using whole genome sequencing: Salmonella resistance to ciprofloxacin
Technical information: Starting January 1, 2020, determination of AMR for human Salmonella changed from using microbroth dilution to AMR prediction from WGS. Validation tests performed by the National Microbiology Laboratory found that prediction of AMR from WGS is accurate and reliable, but the categorization has changed for ciprofloxacin. With AMR prediction, most isolates are reported as non-resistant (susceptible (S) or intermediate (I)), or resistant (R). However, for ciprofloxacin, the method does not discriminate between intermediate and resistant, and results are reported as susceptible (S) or non-susceptible (I/R).
The impact: Prior to 2020, using microbroth dilution, the overall frequency of ciprofloxacin resistance in Salmonella from humans was less than 5%. From 2020 to 2022, using WGS, the overall frequency of Salmonella isolates that were non-susceptible to ciprofloxacin was higher (more than 15%). This difference was larger for specific serovars (e.g., S. Enteritidis). There is work underway to harmonize findings for comparison before and after the widespread implementation of WGS for human Salmonella. Whole genome sequencing has been applied in various CIPARS components to contextualize and better understand the findings. CIPARS is looking forward to further expansion of this powerful tool in the understanding of the molecular epidemiology of AMR, including the broader implementation across all CIPARS components.
References
- Reference 1
-
Health Canada. Categorization of Antimicrobial Drugs Based on Importance in Human Medicine (version April 2009). Available at: https://www.canada.ca/en/health-canada/services/drugs-health-products/veterinary-drugs/antimicrobial-resistance/categorization-antimicrobial-drugs-based-importance-human-medicine.html. Accessed on January 18, 2024.
- Reference 2
-
Details of this change and its impact on reporting are described at the end of the document.
- Reference 3
-
Resistance is reported for ceftriaxone; non-susceptibility is reported for ciprofloxacin. See description regarding the change to AMR prediction using WGS at the end of the document.
- Reference 4
-
Samples of raw pork and beef from grocery stores were not tested for Campylobacter.
- Reference 5
-
Enterococcus faecalis are naturally or intrinsically resistant to quinupristin-dalfopristin; therefore data are not reported. No Clinical and Laboratory Standards Institute (CLSI) interpretative criteria for Enterococcus and avilamycin were available, so the 2021 National Antimicrobial Resistance Monitoring System for Enteric Bacteria (NARMS) interpretative criteria for susceptibility testing were used: https://www.fda.gov/media/108180/download. Accessed on February 14, 2024.
- Reference 6
-
For this host, routine laboratory testing only determined species for Enterococcus faecalis and E. faecium. For the remaining Enterococcus isolated, the Enterococcus species was not determined.
- Reference 7
-
For this host, routine laboratory testing only determined species for Enterococcus faecalis and E. faecium. For the remaining Enterococcus isolated, the Enterococcus species was not determined.
- Reference 8
-
For this host, routine laboratory testing only determined species for Enterococcus faecalis and E. faecium. For the remaining Enterococcus isolated, the Enterococcus species was not determined.
- Reference 9
-
For this host, routine laboratory testing did not test for additional Enterococcus species. For the remaining Enterococcus isolated, the Enterococcus species was not determined.
- Reference 10
-
Routine surveillance started in 2019 for feedlot beef cattle and the trend is reported from 2019. Routine surveillance started in 2019 for dairy cattle and the trend is reported from 2019 to 2021. The detection of Salmonella was too low (<30 isolates per year) for robust interpretation of trends in resistance for feedlot cattle. Routine surveillance does not isolate Salmonella from cattle at abattoir, ground beef, or pork as historically the occurrence is below the limit of detection.
- Reference 11
-
Routine surveillance started in 2019 for feedlot beef cattle and the trend is reported from 2019. Routine surveillance started in 2019 for dairy cattle and the trend is reported from 2019 to 2021. Routine surveillance does not isolate Campylobacter from ground beef, or pork as historically the occurrence is below the limit of detection.
Page details
- Date modified: